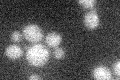
YOR212W
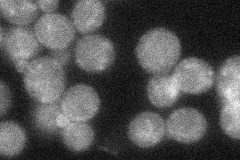
YOR212W
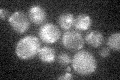
YOR212W

View description
G protein beta subunit, forms a dimer with Ste18p to activate the mating signaling pathway, forms a heterotrimer with Gpa1p and Ste18p to dampen signaling; may recruit Rho1p to the polarized growth site during mating; contains WD40 repeats
Localization:
Intensity:
Fold change:
Significance:
-
C’ GFP library in SD
below threshold15.18 -
N' NOP1pr-GFP in SD

punctate69.8436 -
N' TEF2pr-mCherry in SD

missing0 -
N' NATIVEpr-GFP in SD
punctate35.4181 -
N' TEF2pr-VC and Cyto-VN in SD

#N/A0 -
C’ GFP library in SD+DTT

cytosol13.160.86No -
C’ GFP library in SD+H2O2
cytosol15.130.99No -
C’ GFP library in Starvation Media

cytosol13.960.91No -
C’ GFP library on the background of Pup2-DaMP

below threshold -
C’ GFP library on the background of CCT mutant

below threshold16.91471.11365No
